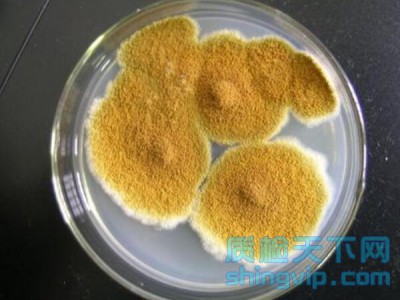
湛江_茂名食品微生物檢測機構,菌落總數檢測一次多少錢
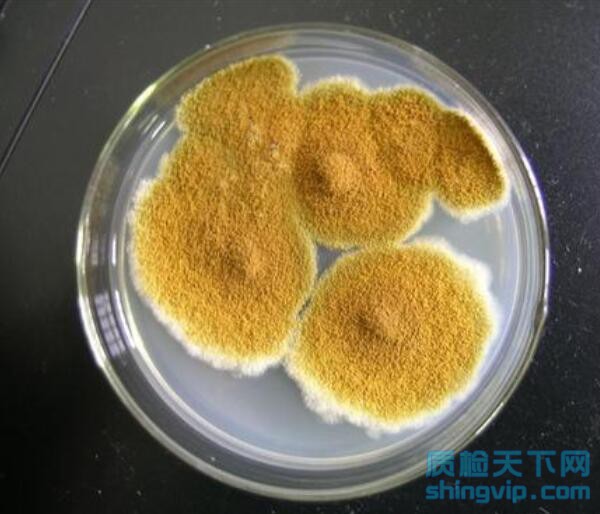
食品微生物檢測

檢測價格
面議
檢測資質
CMA/CNAS
食品微生物的檢測主要包括食品污染指示菌和致病菌含量的測量,并且隨著技術的發展,食品微生物檢測技術從檢測方法上分可以分為常規檢測方法、分子生物學技術、其他檢測技術,每一種檢測技術都各有優缺點,在檢測技術選擇時需要根據具體檢測內容和條件進行選擇,食品微生物檢測技術無論在社會層面還是經濟層面都有著十分重要的意義。
食品微生物檢驗的指標就是根據食品衛生的要求,從微生物學的角度,對不同食品所提出的與食品有關的具體指標要求。我國衛生部頒布的食品微生物指標有菌落總數、大腸菌群和致病菌三項。
1.菌落總數
菌落總數是指食品檢樣經過處理,在一定條件下培養后所得1a或1mL校樣中所含細菌苗落的總數。它可以反應食品的新鮮度、被細菌污染的程度、生產過程中食品是否變質和食品生產的一般衛生狀況等。因此它是判斷食品衛生質量的重要依據之一。
2.大腸菌群
包括大腸桿菌和產氣桿菌的一些中間類型的細菌。這些細菌是寄居于人及溫血動物腸道內的常居菌,它隨著大便排出體外。食品中如果大腸菌群數越多,說明食品受糞便污染的程度越大。故以大腸菌群作為糞便污染食品的衛生指標來評價食品的質量,具有廣泛的意義。
3.致病菌
致病菌即能夠引起人們發病的細菌。對不同的食品和不同的場合,應選擇一定的參考菌群進行檢驗。例如:海產品以副溶血性弧菌作為參考菌群,蛋與蛋制品以沙門氏菌、金黃色葡萄球菌、變形桿菌等作為參考菌群,米、面類食品以蠟樣芽胞桿菌、變形桿菌、霉菌等作為參考菌群,罐頭食品以耐熱性芽胞菌作為參考菌群等等。
4.霉菌及其毒素
我國還沒有制定出霞菌的具體指標,鑒于有很多霉菌能夠產生毒素,引起疾病應該對產毒霉菌進行檢驗。例如:曲霉屬的黃曲留、寄生曲留等,青霉屬的桔青留青留等,鐮刀霉屬的串珠鐮刀舀、禾谷鐮刀霉等等。
5.其他指標
微生物指標還應包括病毒,如肝炎病毒、豬瘟病毒、雞新城疫病毒、馬立克氏病毒、口蹄疫病毒、狂犬病病毒,豬水池病毒等;另外,從食品檢驗的角度考慮,寄生蟲也被很多學者列為微生物檢驗的指標:如旋毛蟲、住肉袍子蟲、蛔蟲、肺吸蟲、弓形體、螨、姜片吸蟲、中華分枝睪吸蟲等等。
佛山市食品檢測服務范圍:廣州市、韶關市、深圳市、珠海市、汕頭市、佛山市、江門市、湛江市、茂名市、肇慶市、惠州市、梅州市、汕尾市、河源市、陽江市、清遠市、東莞市、中山市、潮州市、揭陽市、云浮市。
 一個工作日加急檢測
一個工作日加急檢測 7*24小時快速響應
7*24小時快速響應 十五年檢測經驗
十五年檢測經驗 檢測精準,價格透明
檢測精準,價格透明 超過百個檢測網點
超過百個檢測網點 客服熱線
客服熱線
